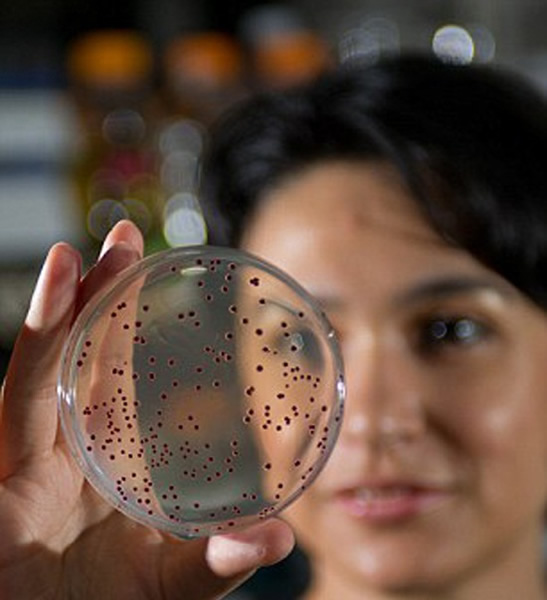

美国佐治亚理工学院实验室成功复活5亿年前“细菌”
迷你“弗兰肯斯坦”类型基因:科学家现已成功复活5亿年前细菌基因,将它们植入现代大肠杆菌中
新的嵌合体生命:远古基因注入现代大肠杆菌中,现已成功繁殖第1000代
据英国每日邮报报道,目前,美国佐治亚理工学院实验室在一项实验中成功复活5亿年前“细菌”,这非常类似于科幻电影《侏罗纪公园》中科学家成功复活恐龙物种。
研究人员将5亿年前细菌基因注入现代大肠杆菌中,这种“弗兰肯斯坦”类型基因能够顽强地存活下来,目前该嵌合体大肠杆菌现已繁衍了1000多代。
科学家希望发现是否这种“远古”细菌能够延续古老基因方式进化,或者出现新的生物体进化方式。美国宇航局天体生物学博士后贝图尔-卡卡尔(Betul Kacar)说:“这非常像倒回和重播生命分子录音带,实验中的新型嵌合体细胞能够快速突变,一些细菌比现代基因更加强壮和健康。”
基 于这种现代细胞体可以从现代生物体中观察远古基因,从而让我们分析是否远古进化轨迹能够重复进行,或者是否生命体能够适应不同的进化路径。卡卡尔说:“这 种已改变的生物体并不是完全健康体,或者适应于现代进化方式,至少在研究初期是这样的。这种发生基因改变的生物体在未来的突变进化中将逐渐适应环境。”
它们的生长速度显著增强,经过500代繁殖,科学家对全部的8个细胞谱系进行了基因排序,从而确定这些细菌是如何适应进化的。不仅它们的适应性以接近现代生物体的水平逐渐增长,一些改变基因谱系的细菌变得比现代细菌更加健康。
当研究人员放大观察时,他们注意到每个远古EF-Tu基因并未出现累积性突变,相反这种远古EF-Tu基因与现代蛋白质相结合的细菌体出现基因突变后具有快速适应性,显著增强了细菌的健康度。
简而言之,到目前为止这些远古基因尚未进化突变,变得更接近于现代细菌体,而是这种嵌合体细菌发现一种新的进化轨迹来增强适应性。
该研究结果发布在近期召开的美国宇航局国际天体生物学科学会议上,科学家们将继续研究嵌合体未来繁殖的后代,观察是否这种蛋白质能够延续历史进化路径或者是否适应新的进化方式。
卡卡尔说:“我们认为这项研究将使我们能够解决关于进化和分子生物学的长期存在疑问。”
文物网版权与免责声明:
一、凡本站中注明“来源:文物网”的所有文字、图片和音视频,版权均属文物网所有,转载时必须注明“来源:文物网”,并附上原文链接。
二、凡来源非文物网的新闻(作品)只代表本网传播该信息,并不代表赞同其观点。
如因作品内容、版权和其它问题需要同本网联系的,请在见后30日内联系邮箱:chief_editor@wenwuchina.com
月度排行
新闻速递
- 2021年度文物保护示范工程公布
- 李白《嘲王历阳不肯饮酒》诗稿考论
- 习近平:不断做强做优做大我国数字经济
- 张同禄80华诞纪念典藏展开幕,景泰蓝《盛世同路》引...
- 为盛世献礼,与第一大党同路!景泰蓝《盛世同路》在沪...
- 国之重器景泰蓝《和平颂宝鉴》入藏敦煌博物馆
- 景泰蓝泰斗张同禄八十华诞纪念典藏展盛大开幕,《盛世...
专题视点MORE
原创推荐MORE
- 文物网培训中心
- 美好时光
- 大家鉴宝—老窑瓷博物馆公益鉴宝活动圆满举行
- 曜变之旅
- 菖蒲河园,一袭釉色染枝头
- 龙泉琮式瓶
- 盛世风袭北京城,金秋月览长安客(下篇)
- 阿富汗珍宝展之:石膏盘上的希腊神话
- 秘色出上林
- 阿富汗珍宝展之:恒河女神雕像